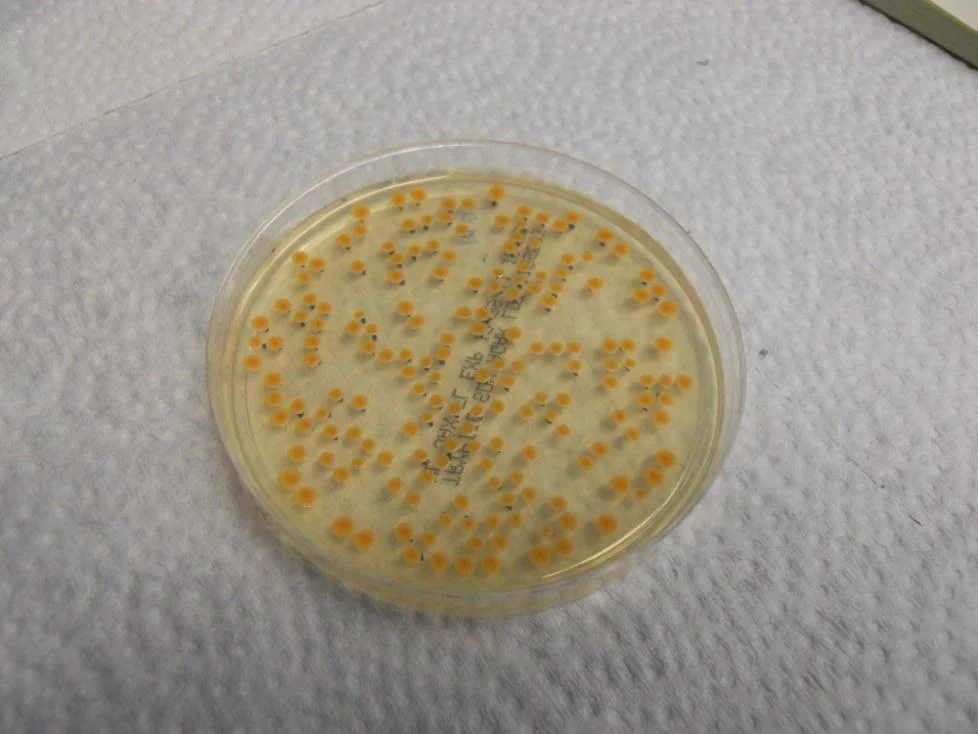

Transportation
Research Results using Bluezone® Fresh Preservation Technology
Refrigerated Storage FFV Research Trials
Introduction
Tests of the anti-microbial performance of the Bluezone Model 300 have been conducted. The test approach used is to disperse a specified quantity of bacterial or mold spores in a Polar King refrigerated trailer and then take air samples at certain time after dispersal. The bacterium used was Bacillus atrophaeus, which has the ability to form a tough, protective endospore which allows the organism to tolerate extreme environmental conditions. Bacterial spores are some of the most UV-resistant micro-organisms. The mold spore used was Penicillium rocqueforti. The tests were performed first without the Bluezone unit operating, to establish a control, and then with the Bluezone unit operating.
Test Method
The Polar King trailer used has an internal volume of approximately 300 cu. ft. The Bluezone unit used in the testing to date was a Model 300 Unit. The test arrangement is illustrated in Figure 1.
Figure 1: Test Arrangement for Microbial Testing
Test Procedures:
- Clean and sterilize the impactor air sampler by wiping thoroughly with alcohol swabs.
- Prepare B. atrophaeus or P. rocqueforti spore solution in a Collison nebulizer.
- Install the nebulizer in the Polar King trailer and connect the compressed air supply to the nebulizer.
- Close the Polar King door.
- Supply compressed air to the nebulizer for a specified period to disperse a fixed quantity of spores into the trailer.
- Wait a specified time with the Bluezone unit EEU on or off, as appropriate.
- Install a tryptic soy agar (TSA) plate (for the bacterial spores) or a malt extract agar (MEA) plate (for the mold spores) in the impactor and sample from the interior of the Polar King trailer by connecting the impactor to a vacuum pump and drawing air at 1 cfm for a specified sample time.
- Remove agar plates from impactor and place in incubator at 35 deg C for 24 hours (for the bacterial spores) or 25 deg C for 3 – 5 days (for the mold spores).
- After incubation period, remove agar plates and count colony forming units (CFUs).
- Convert to CFU/m3 based on known sample times.
The impactor and associated vacuum pump are shown in Figure 2. It is important to establish a spore dispersion and sampling method which will produce a high enough number of CFUs under the baseline (no Bluezone) conditions so that any sporicidal effect of the Bluezone can be discerned. By its very nature, microbial testing leads to large variability in data, hence the need for multiple repeat samples. Increasing the number of spores dispersed, or the volume of air sampled, will increase the number of spores directed via the sample jets onto the agar. The impactor has a nozzle plate with 400 very small diameter nozzles which direct the sample onto the TSA medium. The CFU is thus established where the jet impacts the agar. Sampling for too long, or dispersing too many spores can lead to multiple CFUs at each jet impact location, which makes them very difficult to separate and count properly. So a balance must be struck such that good quality data can be obtained.
By trial and error, we arrived at a protocol which called for dispersion using the nebulizer for 5 minutes and sampling from each impactor for 1 to 10 minutes, depending on the elapsed time from spore dispersal. In order to simulate the continuous generation of bacterial spores, we dispersed spores for five minutes every hour for several hours. Samples were taken either 30 minutes or 1 hour after dispersal, apart from the last samples, which were taken one and a half and two hours after dispersal.
Figure 2 Impactor and vacuum pump used in air sampling for bacterial spores.
Figure 3 Bacillus atrophaeus colonies after incubation
Test Results
A TSA plate after sampling and incubation is shown in Figure 3. Bacterial colonies are established where the jets directed via the impingement nozzles impact the agar. Test results are summarized in Figure 4 & 5 below, for B. atrophaeus and P. rocqueforti, respectively. For the two conditions (Bluezone off and Bluezone on), all data were collected in one continuous experiment, with repeated dispersals and samplings producing the multiple data points at the specified time. The time in Figure 4 is the time between spore dispersal and air sampling.
With the Bluezone off, the baseline data shows that the CFU count for both the bacterial and mold spores is stable for at least two hours. In the case of B. atrophaeus, a loading of ~70,000 CFU/m3 was achieved, whereas for the P. rocqueforti a loading of ~1,500 CFU/m3 was achieved.
Figure 4: Bacillus atrophaeus CFU Counts with and without Bluezone Operation.
Figure 5 Penicillium rocqueforti CFU Counts with and without Bluezone Operation.
However, with the Bluezone Model 300 turned on, the CFU count is reduced by at least three order of magnitude (three log kill) compared to the natural decay. Counts after one hour are reduced to ~100 per m3 for the bacterial spores and ~10 per m3 for the mold spores. After two hours the counts are ~ 1 per m3 for both organisms. The Bluezone is thus responsible for a kill of greater than 99% after one hour and greater than 99.9% after two hours, relative to the baseline counts.
Conclusion
In carefully controlled tests, a Bluezone Model 300 has been shown to repeatedly demonstrate a two orders of magnitude kill of most resistant bacterial spores and mould spores in a refrigerated trailer after only one hour.